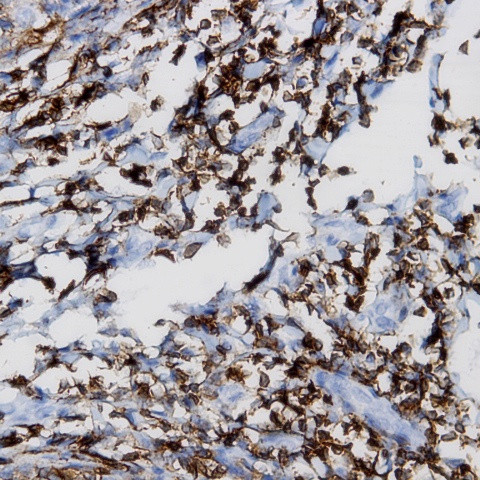
p18/INK4C Antibody in Immunohistochemistry (Paraffin) (IHC (P))

Search
AbboMax
p18/INK4C Polyclonal Antibody
{{$productOrderCtrl.translations['antibody.pdp.commerceCard.promotion.promotions']}}
{{$productOrderCtrl.translations['antibody.pdp.commerceCard.promotion.viewpromo']}}
{{$productOrderCtrl.translations['antibody.pdp.commerceCard.promotion.promocode']}}: {{promo.promoCode}} {{promo.promoTitle}} {{promo.promoDescription}}. {{$productOrderCtrl.translations['antibody.pdp.commerceCard.promotion.learnmore']}}
图: 1 / 1
p18/INK4C Antibody (500-13744) in IHC (P)

产品信息
500-13744
种属反应
宿主/亚型
分类
类型
抗原
偶联物
形式
浓度
纯化类型
保存液
内含物
保存条件
运输条件
产品详细信息
Positive control: Human brain
Cellular location: Nuclear.
靶标信息
The protein encoded by this gene is a member of the INK4 family of cyclin-dependent kinase inhibitors. This protein has been shown to interact with CDK4 or CDK6, and prevent the activation of the CDK kinases, thus function as a cell growth regulator that controls cell cycle G1 progression. Ectopic expression of this gene was shown to suppress the growth of human cells in a manner that appears to correlate with the presence of a wild-type RB1 function. Studies in the knockout mice suggested the roles of this gene in regulating spermatogenesis, as well as in suppressing tumorigenesis. Two alternatively spliced transcript variants of this gene, which encode an identical protein, have been reported.
仅用于科研。不用于诊断过程。未经明确授权不得转售。
篇参考文献 (0)
生物信息学
蛋白别名: CDK6 inhibitor p18; cyclin-dependent inhibitor; Cyclin-dependent kinase 4 inhibitor C; Cyclin-dependent kinase 6 inhibitor; cyclin-dependent kinase 6 inhibitor p18; cyclin-dependent kinase inhibitor 2C (p18, inhibits CDK4); p18-INK4c; p18-INK6
基因别名: C77269; CDKN2C; CDKN6; INK4C; p18; p18-INK4C; p18-INK6; p18INK4c
UniProt ID: (Human) P42773, (Mouse) Q60772
Entrez Gene ID: (Human) 1031, (Rat) 54238, (Mouse) 12580